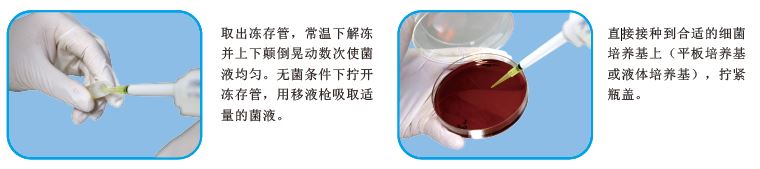

【用途】用于军团菌的保存
【包装方式】
塑料管装1ml,单支独立包装,更防漏,免污染
【产品原理】
冻存管中含有添加了甘油的液体培养基,冻存管接种上细菌后,可放置于-20℃或-80℃环境中长期保存。当需要复苏菌株时,用移液枪吸取适量的菌液直接接种到合适的细菌培养基上(平板培养基或液体培养基)。
【菌种保存】
1.使用前,用油性笔在每个冻存管上标记上细菌的名称。每支冻存管只可接种一种细菌;
2.在无菌条件下,打开冻存管的螺旋瓶盖,用接种环挑取18-24小时新鲜细菌纯培养物,放入冻存液中。拧紧瓶盖,来回颠倒晃动(或用移液枪吹打)使细菌乳化,配成大约3-4麦氏比浊度的菌悬液。记录下接种细菌的详细情况;
3.将接种完细菌的冻存管放在-20℃或-80℃冰箱中保存。
【菌株复苏】
1.取出冻存管,常温下解冻并上下颠倒晃动数次使菌液均匀。无菌条件下拧开冻存管,用移液枪吸取适量的菌液直接接种到合适的细菌培养基上(平板培养基或液体培养基),拧紧瓶盖;
2.尽可能快地将冻存管放回原来的保存环境,温度过多改变将减弱细菌的生存能力;
【保存条件】
1.未经使用的冻存管可在室温保存12个月;已经接种的冻存管在-20℃可保存24个月或-80℃可保存5年以上。
2.在接种之前有如下情况产生,该冻存管不得使用:
a.瓶子有漏液情况发生;
b.冻存管内的冻存保护液混浊;
c.超过有效保存期。
3.当丢弃使用过的或部分使用过的冻存管时,应注意生物危害的预防。
【菌种保存流程】
【菌种复苏流程】
军团菌菌种保存管微生物灵敏度试验:
接种以下质控菌株,放置36℃需氧培养72小时。

相关资料: